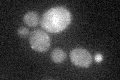
YER054C
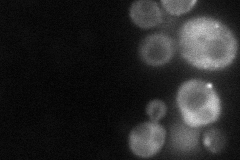
YER054C
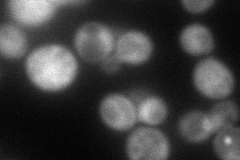
YER054C
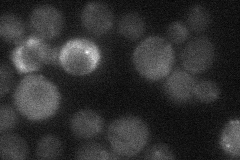
YER054C
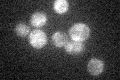
YER054C

View description
Putative regulatory subunit of the protein phosphatase Glc7p, involved in glycogen metabolism; contains a conserved motif (GVNK motif) that is also found in Gac1p, Pig1p, and Pig2p
Localization:
Intensity:
Fold change:
Significance:
-
C’ GFP library in SD
punctate24.63 -
N' NOP1pr-GFP in SD
cytosol,punctate66.771 -
N' TEF2pr-mCherry in SD
cytosol89.7438 -
N' NATIVEpr-GFP in SD
cytosol,punctate27.7326 -
N' TEF2pr-VC and Cyto-VN in SD

below threshold25.0083 -
C’ GFP library in SD+DTT

punctate28.41.15No -
C’ GFP library in SD+H2O2

punctate23.380.94No -
C’ GFP library in Starvation Media
punctate30.681.24No -
C’ GFP library on the background of Pup2-DaMP

punctate -
C’ GFP library on the background of CCT mutant

punctate25.24221.02446No
